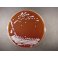
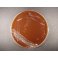

Brain Heart Infusion Agar MM0175
Description
Use and description of Brain Heart Infusion Agar :
Field : Clinical microbiology
Special field : Aerobe application, Blood agar, Chocolate agar,Aerobe spore forming
Organisms : Enterococcus,Campylobacter,Helicobacter,Staphylococcus,Listeria,Neisseria,Nutritious bacteria, Aeromonas,Pseudomonas URI Pathogen,Enterobacteriaceae Salmonella, Shigella ,Yersina, Lactobacillus
Application :
-Medium for the cultivation of a wide variety of fastidious microorganisms.
-Supplemented with sheep or horse blood can be used as a Blood Agar
-Supplemented with heat-hemolysed sheep or horse blood can be used as Chocolate Agar
- Media for isolation
- Media for Neisseriaceae
Special field of application :
- Histoplasma, Blastomyces culture
Downloads
Newsletter
Address: 10130 Tallin Kiriku Tn 6, Hungary
Phone: +36306013634, Fax: ,
Support: support@micromediatradinghouse.com